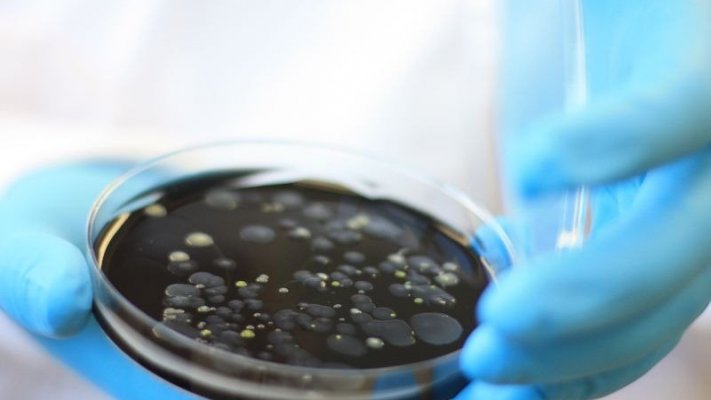

Piscinas Municipais de Albufeira encerradas devido à presença de 'legionella'
As Piscinas Municipais de Albufeira, no distrito de Faro, estão encerradas temporariamente a partir de hoje, devido à presença de ‘legionella’, anunciou a autarquia.
“Na sequência de relatórios laboratoriais de domingo, dia 30 de novembro, que detetaram resultados positivos à ‘legionella’ nas amostras recolhidas no Complexo de Piscinas Municipais de Albufeira às águas quentes sanitárias, o Município decidiu encerrar temporariamente aquele equipamento desportivo a partir de amanhã [hoje], dia 02 de dezembro, lê-se numa nota da autarquia publicado nas redes sociais.
O Município sublinha que no domingo, face à classificação de risco, foram efetuados todos os procedimentos de segurança e tratamentos necessários por parte da empresa responsável pela manutenção, nomeadamente operações de limpeza e desinfeção de choque dos sistemas e ramais de águas quentes sanitárias.
Por outro lado, estão a ser realizadas “novas amostras para avaliação preliminar” e, posteriormente, decorridos 10 a 15 dias da intervenção, serão recolhidas amostras para uma primeira avaliação da eficácia das medidas corretivas adotadas.
A nota refere que o presidente da Câmara de Albufeira, Rui Cristina e o vice-presidente Jorge Carmo, responsável pelo pelouro do Desporto, “estão a acompanhar a situação desde o primeiro minuto”.
A situação está a ser coordenada com as autoridades de Saúde Pública para a rápida resolução do problema, com vista a que o complexo “possa reabrir novamente, após a garantia total de segurança para a saúde dos utentes”, acrescenta.
A presença de ‘legionella’ já levou a Federação Portuguesa de Natação a ter de procurar outro local para a realização da Prova Zonal de Juvenis - Zona Sul, marcada para os dias 06, 07 e 08 de dezembro, lê-se numa nota divulgada nas redes sociais.
“A nova localização será comunicada o mais brevemente possível, assim que estejam reunidas todas as condições de segurança e qualidade necessárias para a realização da prova”, afirma aquela entidade.
A ‘legionella’ é um tipo de bactéria responsável por uma doença respiratória chamada Doença dos Legionários, um tipo de pneumonia considerada atípica.
A infeção não se transmite de pessoa para pessoa nem pela ingestão de água, mas sim pela inalação de gotículas de água contaminada em suspensão no ar.

Sociedade de Emergência teme retrocesso no socorro pré-hospitalar

Deputados do PS na AR questionam transporte de mercadorias perigosas pela TAP

Hantavírus: Francês retirado do cruzeiro afetado por hantavírus com sintomas no voo

Hantavírus: Diretor da OMS afirma que risco de contágio "é baixo"

Comissão de trabalhores acusa Governo de querer desmantelar INEM com nova reforma

Hantavírus: Aviões começam a repatriar passageiros de navio a partir das Canárias

Hantavírus: Papa agradece hospitalidade das Canárias por permitirem desembarque de navio

Hantavírus: Médicos britânicos enviados de paraquedas para ilha Tristão da Cunha

Hantavírus: Arranca desembarque de ocupantes de cruzeiro nas Canárias

Hantavírus. Operação com cruzeiro nas Canárias termina segunda-feira à tarde

Hantavírus: Cruzeiro MV Hondius dá entrada no porto de Granadilla, em Tenerife
